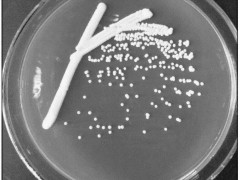

黑龙江省科技厅副厅长韩金华、我校校长助理沈毅、中国微生物学会环境微生物学专业委员会主任周宁一分别致辞。简浩然环境微生物基金会管理委员会代表、广东省微生物研究所孙国萍研究员介绍了简浩然生平及简浩然环境微生物基金的由来,并宣读简浩然环境微生物优秀论文奖及简浩然优秀工程奖获奖名单。环境微生物学专委会副主任刘双江、许平、蒋建东、吴晓磊等出席大会开幕式,并为优秀论文奖获得者颁发证书和奖金。大会开幕式由大会组委会主席、我校邢德峰教授主持。
大会邀请我校任南琪院士、中国科学院水生生物研究所张承才研究员就生物质规模化生物制氢关键科学技术等主题作特邀大会报告。17位专家作大会报告。会议设立了环境微生物学前沿、污染物生物降解与环境修复、环境微生物组学、微生物资源化与能源化、新兴污染物生物降解等6个分会场,106位专家学者进行报告交流。
大会共收到论文及摘要314篇,并编制了《第二十二次全国环境微生物学学术研讨会论文摘要集》。大会共收到120份Poster,14位年轻学者进行2分钟的Flash Talk交流,最终评选出10个优秀Flash Talk奖和20篇优秀Poster奖。大会还收到16份摄影作品,评选出5个优秀摄影作品奖,并分别颁发证书和奖金。
会议期间还举行了编辑与读者作者交流会、青年学子与专家面对面交流会、第六届环境微生物学专业委员会第四次会议。
本次大会由我校环境学院、城市水资源与水环境国家重点实验室、城市水资源开发利用(北方)国家工程研究中心、污染物处理及能源化国际联合研究中心承办,黑龙江大学生命学院、哈尔滨师范大学,东北农业大学和黑龙江八一农垦大学协办。

大会现场

黑龙江省科技厅副厅长韩金华致辞

校长助理沈毅致辞

环境微生物学专委会主任周宁一致辞

大会主席邢德峰主持开幕式

任南琪院士作特邀大会报告

优秀Flash Talk奖颁奖

优秀Poster奖颁奖

编辑与读者作者见面会

会旗交接